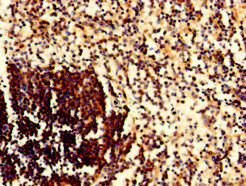

CD79A Antibody
-
中文名稱:CD79A兔多克隆抗體
-
貨號:CSB-PA004957LA01HU
-
規格:¥440
-
圖片:
-
Immunohistochemistry of paraffin-embedded human tonsil tissue using CSB-PA004957LA01HU at dilution of 1:100
-
Immunohistochemistry of paraffin-embedded human spleen tissue using CSB-PA004957LA01HU at dilution of 1:100
-
Immunofluorescent analysis of HepG2 cells using CSB-PA004957LA01HU at dilution of 1:100 and Alexa Fluor 488-congugated AffiniPure Goat Anti-Rabbit IgG(H+L)
-
-
其他:
產品詳情
-
產品名稱:Rabbit anti-Homo sapiens (Human) CD79A Polyclonal antibody
-
Uniprot No.:
-
基因名:
-
別名:CD79A; IGA; MB1; B-cell antigen receptor complex-associated protein alpha chain; Ig-alpha; MB-1 membrane glycoprotein; Membrane-bound immunoglobulin-associated protein; Surface IgM-associated protein; CD antigen CD79a
-
宿主:Rabbit
-
反應種屬:Human
-
免疫原:Recombinant Human B-cell antigen receptor complex-associated protein alpha chain protein (70-142AA)
-
免疫原種屬:Homo sapiens (Human)
-
標記方式:Non-conjugated
本頁面中的產品,CD79A Antibody (CSB-PA004957LA01HU),的標記方式是Non-conjugated。對于CD79A Antibody,我們還提供其他標記。見下表:
-
克隆類型:Polyclonal
-
抗體亞型:IgG
-
純化方式:>95%, Protein G purified
-
濃度:It differs from different batches. Please contact us to confirm it.
-
保存緩沖液:Preservative: 0.03% Proclin 300
Constituents: 50% Glycerol, 0.01M PBS, pH 7.4 -
產品提供形式:Liquid
-
應用范圍:ELISA, IHC, IF
-
推薦稀釋比:
Application Recommended Dilution IHC 1:20-1:200 IF 1:50-1:200 -
Protocols:
-
儲存條件:Upon receipt, store at -20°C or -80°C. Avoid repeated freeze.
-
貨期:Basically, we can dispatch the products out in 1-3 working days after receiving your orders. Delivery time maybe differs from different purchasing way or location, please kindly consult your local distributors for specific delivery time.
-
用途:For Research Use Only. Not for use in diagnostic or therapeutic procedures.
相關產品
靶點詳情
-
功能:Required in cooperation with CD79B for initiation of the signal transduction cascade activated by binding of antigen to the B-cell antigen receptor complex (BCR) which leads to internalization of the complex, trafficking to late endosomes and antigen presentation. Also required for BCR surface expression and for efficient differentiation of pro- and pre-B-cells. Stimulates SYK autophosphorylation and activation. Binds to BLNK, bringing BLNK into proximity with SYK and allowing SYK to phosphorylate BLNK. Also interacts with and increases activity of some Src-family tyrosine kinases. Represses BCR signaling during development of immature B-cells.
-
基因功能參考文獻:
- The incidence of MYD88 and CD79B mutations in patients with CD5(+) DLBCL is lower than that in patients with DLBCL-SS, suggesting that CD5(+) DLBCL is not the same disease as DLBCL-SS in terms of gene mutation status. PMID: 27915469
- Phosphorylation of CD79a causes a decrease in helical propensity in the C-terminal region, for CD79b, the opposite was observed and phosphorylation resulted in an increase of helical propensity in the C-terminal part. PMID: 24769851
- High intensity of caries is associated with increased levels of some salivary components - sIgA, histatin-5 and lactoperoxidase. PMID: 24974109
- CD79a plays a functional role in the tumor promoting effects of myeloid cells, and may represent a novel target for cancer therapy. PMID: 24146823
- STN produced significant antitumor effects in a mouse xenograft model of CD79A/B-mutated DLBCL. PMID: 21324920
- CD79a may be helpful marker in the differential diagnosis of classical Hodgkin's lymphoma and primary mediastinal B-cell lymphoma PMID: 20102401
- Unlike the B29 octamer motif, the mb-1 octamer motif does not have the essential sequence required for OBF-1/Bob1 interaction, therefore its promoter is not transactivated by OBF-1/Bob1. PMID: 11907094
- B cell-restricted mb-1 gene: expression, function, and lineage infidelity. Review. PMID: 12403343
- There is a somatic hypermutation of this gene in B-cell lymphoma and multiple myeloma. PMID: 12651942
- Results indicate that PAX5 is a more specific marker than CD79a for B-cell ALL diagnosis. PMID: 15492262
- lower levels of B-cell receptor surface expression observed in chronic lymphocytic leukemia are accounted for by an impaired glycosylation and folding of the mu and CD79a chains. PMID: 15591116
- FISH findings indicate that CD79a, despite its specificity for B-cell differentiation, represented the aberrant presence of a B-cell antigen in leukemias of distinct myeloid linage. PMID: 16271957
- Acute leukemia with t(8;21) coexpresses CytCD79a represent biphenotypic acute leukemia. PMID: 17350472
- Anti-CD79b antibodies downregulated surface B-cell receptor and were trafficked to the lysosomal-like major histocompatibility complex class II-positive compartment of a mouse xenograft model of non-Hodgkin lymphoma. PMID: 17374736
- Ig-alpha was phosphorylated in all myeloma IgG BCR isolates, the 31-kD variant being phosphorylated most frequently. It was not phosphorylated in normal control B cells. PMID: 17701175
- Median survival time of cytoplasmic CD79 alpha positive group was shorter than that of cytCD79a negative group in acute myeloid leukemia. PMID: 18160827
顯示更多
收起更多
-
相關疾病:Agammaglobulinemia 3, autosomal recessive (AGM3)
-
亞細胞定位:Cell membrane; Single-pass type I membrane protein.
-
組織特異性:B-cells.
-
數據庫鏈接:
Most popular with customers
-
YWHAB Recombinant Monoclonal Antibody
Applications: ELISA, WB, IHC, IF, FC
Species Reactivity: Human, Mouse, Rat
-
Phospho-YAP1 (S127) Recombinant Monoclonal Antibody
Applications: ELISA, WB, IHC
Species Reactivity: Human
-
-
-
-
-
-